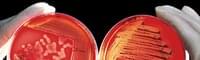
Évolution de carrière - Biologiste

Biologiste - Fiche métier : tâches, compétences et formation
Consultez tous les offres d'emplois pour Biologiste
Biologiste - Définition et fiche métier

Le biologiste est un scientifique qui étudie les mécanismes cellulaires et moléculaires, ainsi que les processus chimiques et physiques qui se produisent dans les organismes vivants (hommes, animaux, plantes et bactéries), leur génétique et leur relation avec l'environnement extérieur, y compris les processus de développement, évolution et interaction avec d'autres organismes.
Mais que fait exactement un biologiste ?
Le biologiste observe la nature et la vie qui s'y trouve, fait des expériences en laboratoire, utilise des méthodes de recherche pour comprendre le fonctionnement des organismes au niveau moléculaire et cellulaire, et il étudie les processus vitaux. L'une des tâches du biologiste consiste à identifier et comprendre les réactions chimiques biologiques qui permettent de garder l'organisme en vie (respiration cellulaire, métabolisme, photosynthèse de la chlorophylle, etc.) et les structures moléculaires qui se forment pour maintenir l'environnement interne de l'organisme stable et en équilibre (homéostasie).
Pour ce faire, les biologistes analysent au microscope les cellules, tissus et échantillons de matériaux biologiques et exécutent des analyses moléculaires, microbiologiques et biochimiques sur les composés ou les substances simples.
La biologie est une science qui a différents domaines d'application : les diplômés en biologie trouvent par exemple souvent du travail dans le secteur sanitaire, dans les hôpitaux et les laboratoires d'analyses cliniques. Les activités du biologiste clinique se concentrent principalement en laboratoire : il effectue des analyses microbiologiques, génétiques et bactériologiques sur l'échantillon biologique prélevé (de sang par exemple) pour le diagnostic ou la prévention des maladies, ou pour la recherche, afin de tester de nouveaux médicaments et vaccins.

Le profil du biologiste est aussi relativement commun dans le secteur alimentaire, où il peut trouver du travail comme biologiste alimentaire ou biologiste nutritionniste. Le biologiste alimentaire travaille pour des entreprises alimentaires : il est chargé des analyses et du contrôle qualité des matières premières, des semi-élaborés et des produits finis, afin de vérifier que les modalités de préparation, conservation et transport des aliments respectent les normes hygiéniques, sanitaires et HACCP. Il s'agit d'analyses de type préventif, qui permettent d'identifier les risques potentiels pour la santé des consommateurs.
Le biologiste nutritionniste s'occupe en revanche directement de l'alimentation humaine : il évalue les besoins nutritionnels et énergétiques d'une personne et élabore des régimes personnalisés, afin d'assurer le bon apport énergétique à l'organisme.
Un biologiste peut également travailler dans le secteur du cosmétique, comme cosmétologue : il effectue des analyses et contrôles qualité sur les produits cosmétiques, comme les crèmes et les rouges à lèvres, et surveille les différentes phases de production, des matières premières à la formule du produit cosmétique et jusqu'à sa commercialisation. Les biologistes peuvent encore trouver un emploi dans les entreprises du secteur chimique et pharmaceutique, en particulier pour les analyses de laboratoire et de contrôle qualité des laboratoires pharmaceutiques.
Certains biologistes travaillent dans le domaine de la protection de l'environnement et la sauvegarde de la biodiversité : ils effectuent des échantillonnages et analyses de laboratoire pour l'agriculture et l'industrie, par exemple pour surveiller la présence de substances polluantes dans l'environnement et l'eau, ou pour évaluer le bien-être animal dans les élevages. Un biologiste peut aussi se consacrer à l'étude et à la recherche sur les aspects de la vie marine comme biologiste marin.
La recherche et l'enseignement offrent également des débouchés pour les biologistes : ils peuvent devenir professeurs de biologie dans les écoles, ou trouver un poste de chercheur dans les universités, laboratoires et centres de recherche publics ou privés, dans des équipes avec d'autres scientifiques et techniciens de laboratoire.
Les experts en sciences de la biologie travaillent par exemple dans le cadre de la recherche génétique, de la recherche sur le cancer ou dans la recherche pour la production de produits biologiques et biodégradables.
Emplois similaires : Biologie Cellulaire, Biologie Moléculaire, Master Biologie, Microbiologie, Stage Biologie, Technicien Biologiste
Biologiste - Tâches

Les tâches du biologiste changent en fonction du contexte professionnel. En général, parmi les tâches confiées aux biologistes figurent :
- Récolter des données et échantillons
- Effectuer des analyses microbiologiques sur les tissus, les matériaux et les liquides biologiques
- Effectuer des analyses chimiques et biologiques et des contrôles qualité
- Analyser les données recueillies selon une méthode scientifique et statistique
- Rédiger les dossiers et rapports sur les résultats des analyses
- Faire des recherches et observations sur le terrain
- Faire des expériences
- Fournir des conseils dans le domaine biologique
Devenir biologiste - Formation et qualités requises

Pour devenir biologiste il faut une maîtrise en biologie, sciences de la biologie ou autres du même type. Le parcours formatif traite de matières telles que la chimie, la génétique moléculaire, la cytologie, l'histologie, la taxonomie, la botanique, la zoologie, l'écologie et autres matières scientifiques (mathématiques, physique, statistique, informatique).
La formation du biologiste prévoit généralement une période de pratique ou de stage en laboratoire, afin de se familiariser avec les méthodes de travail, appareils et instruments typiques d'un laboratoire d'analyse (microscope, pH-mètre, incubateurs, kit d'électrophorèse, minéralisateurs pour l'analyse des métaux lourds, etc.), et apprendre à travailler en équipe.
Il existe différentes spécialisations après la maîtrise, qui permettent d'acquérir des compétences et titres spécifiques pour travailler dans certains domaines, comme la génétique, l'écologie, la biologie marine, la cosmétologie ou les biotechnologies.
Quel que soit le secteur de spécialisation, le biologiste doit respecter les normes juridiques et déontologiques qui réglementent la profession – comme les normes pour l'accès à la profession et le code de déontologie de la profession de biologiste.
Il est également important de se mettre à jour continuellement, en participant à des congrès, lisant des revues et publications scientifiques du secteur, en échangeant et collaborant avec d'autres biologistes, scientifiques et spécialistes des sciences de la vie.
Compétences d'un biologiste
Les principales compétences qu'un biologiste doit avoir sont les suivantes :
- Connaissance des méthodes et techniques d'étude biologique
- Capacité de relevé et analyse des données
- Compétences opérationnelles dans les analyses de laboratoire chimique et biologique
- Capacité d'effectuer des recherches et expériences avec une méthode scientifique
- Capacité d'utiliser des instruments et appareils de laboratoire
- Curiosité et capacité d'observation
- Capacités analytiques et de résolution des problèmes
- Soin et précision
- Capacité de travailler en équipe
Biologiste - Débouchés et carrière
Au terme de ses études, un biologiste peut trouver du travail dans différents secteurs et entreprendre des parcours de carrière différents.
Un biologiste qui travaille comme technicien de laboratoire peut devenir responsable de laboratoire d'analyse (dans le domaine clinique, microbiologique, chimique et biologique, environnemental, etc.), mais aussi responsable du contrôle qualité dans des entreprises alimentaires, pharmaceutiques, ou laboratoires de production de cosmétiques. Il peut participer à des projets de recherche - par exemple dans le domaine de la biologie moléculaire, de la génétique, de la biologie marine, de la pollution de l'environnement, dans une équipe composée d'autres scientifiques et chercheurs, éventuellement internationale, et en prendre la direction comme team leader ou responsable de projet de recherche.
Certains se tournent en revanche vers l'enseignement, et deviennent professeurs de biologie et autres matières scientifiques de l'enseignement secondaire ou académique.
Un biologiste peut aussi choisir de travailler comme consultant indépendant et collaborer avec les entreprises et organismes, par exemple dans le domaine de la protection de l'environnement, de la sécurité alimentaire ou des certifications sur l'utilisation des OGM.
Les principaux attraits du métier de biologiste
La profession de biologiste est adaptée à ceux qui nourrissent un intérêt pour les sciences de la vie, sont curieux et attentifs à l'environnement qui les entoure. La biologie est une science qui joue un rôle très important dans le soin et la prévention des maladies, la protection de l'environnement et, en général, l'amélioration des conditions de vie de l'homme, des animaux et des plantes, grâce aux progrès de la science et à des projets de recherche d'avant-garde.
Une maîtrise en biologie ouvre la porte à de nombreux débouchés professionnels – dans la recherche, l'industrie, dans le domaine clinique ou l'enseignement – avec des perspectives de carrière intéressantes.
Le salaire du biologiste varie en fonction du contexte professionnel, et il est généralement plus élevé pour les candidats qui disposent de spécialisations, doctorats ou qualifications particulières.




